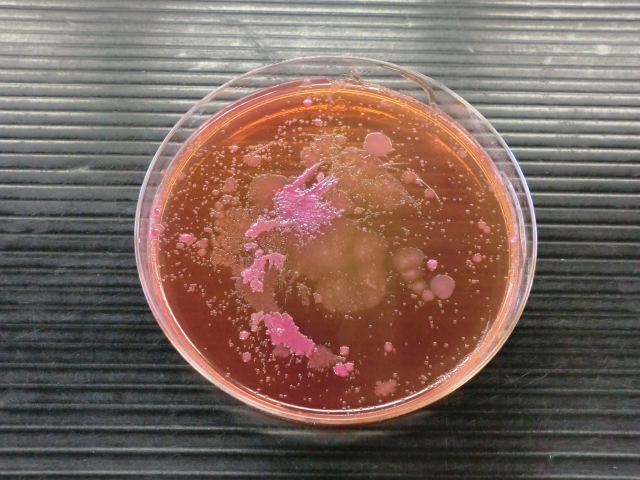
性病検査の意義：何がわかり、なぜ重要なのか

性病検査は、我々が自身の健康を理解し、適切に管理するための重要なツールの1つです。しかしながら、多くの人々がこの検査の真の価値を完全に理解しているとは言えません。では、性病検査は具体的に何を示し、それがなぜあなたの健康と将来にとって重要なのでしょうか?
まず、性病検査は、あなたが特定の性病を持っているかどうかを判定します。これは一見すると単純なことのように思えますが、その意味は深く、多方面にわたる影響を持ちます。なぜなら、性病は無症状で進行することが多いからです。つまり、あなたが感じることのない症状を伴う感染症を持っている可能性があるのです。
それがなぜ重要なのでしょうか?それは、未治療の性病が長期的な健康問題を引き起こす可能性があるからです。例えば、クラミジアや淋病は不妊症を引き起こす可能性があり、また梅毒やHIVは適切な治療がなければ生命を脅かす可能性があります。
さらに、性病は他人に感染する可能性があるため、検査によって自身が感染源である可能性を知ることは、パートナーや将来のパートナーの健康を守るためにも重要です。
性病検査はまた、あなたが自身の健康状態を理解し、適切な治療やケアを受けるための重要なステップでもあります。陽性であれば適切な治療を開始し、陰性であればその安心感を得ることができます。
最後に、定期的な性病検査は、自己ケアと自己尊重の一部であり、自分自身の身体と健康に対する責任を果たす方法の一つです。あなたの身体はあなた自身が最も良く理解し、ケアできるものです。性病検査を受けることで、あなたは自己啓発と自己ケアに努力していることを示し、あなた自身と他人を尊重していることを示すのです。
したがって、性病検査は、単にある種の病気を持っているかどうかを判断するだけでなく、あなた自身の健康を管理し、あなたの生活に大きな影響を及ぼす可能性がある問題についての自覚を高める重要な手段なのです。これは、自己ケアの一環として、また、あなたのパートナーや他の人々を尊重し、守るために、定期的に性病検査を受けるべき理由です。
自身の健康はあなた自身の手に握っているのです。性病検査を受けることで、あなたは自分自身の身体と健康に対する責任を果たし、自分自身と他人を守ることができます。これはあなたが自分自身を大切にし、自己ケアをする一部なのです。
結果がどうであれ、あなたは一人ではありません。サポートを求め、情報を得て、次のステップを考えていきましょう。あなたの健康と幸せは、あなた自身が最も優先すべきことです。

コメント